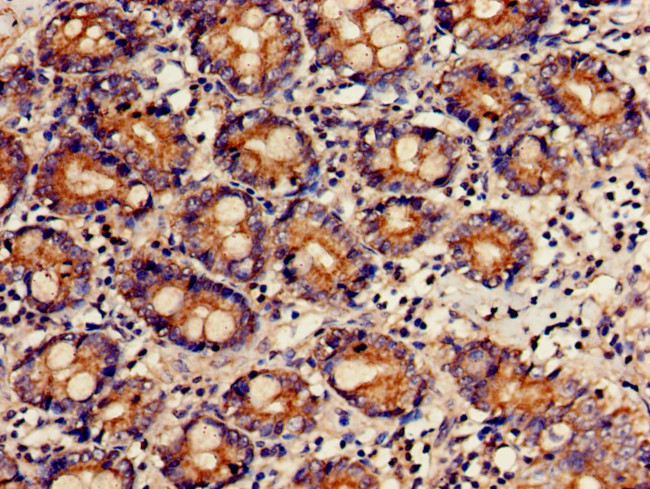
FCHSD2 Antibody in Immunohistochemistry (Paraffin) (IHC (P))

Search
Invitrogen
FCHSD2 Polyclonal Antibody
{{$productOrderCtrl.translations['antibody.pdp.commerceCard.promotion.promotions']}}
{{$productOrderCtrl.translations['antibody.pdp.commerceCard.promotion.viewpromo']}}
{{$productOrderCtrl.translations['antibody.pdp.commerceCard.promotion.promocode']}}: {{promo.promoCode}} {{promo.promoTitle}} {{promo.promoDescription}}. {{$productOrderCtrl.translations['antibody.pdp.commerceCard.promotion.learnmore']}}
产品信息
PA5-97739
种属反应
宿主/亚型
分类
类型
抗原
偶联物
形式
浓度
规格
纯化类型
保存液
内含物
保存条件
运输条件
RRID
靶标信息
Adapter protein that plays a role in endocytosis via clathrin-coated pits. Contributes to the internalization of cell surface receptors, such as integrin ITGB1 and transferrin receptor (PubMed:29887380). Promotes endocytosis of EGFR in cancer cells, and thereby contributes to the down-regulation of EGFR signaling (PubMed:30249660). Recruited to clathrin-coated pits during a mid-to-late stage of assembly, where it is required for normal progress from U-shaped intermediate stage pits to terminal, omega-shaped pits (PubMed:29887380). Binds to membranes enriched in phosphatidylinositol 3,4-bisphosphate or phosphatidylinositol 3,4,5-trisphosphate (PubMed:29887380). When bound to membranes, promotes actin polymerization via its interaction with WAS and/or WASL which leads to the activation of the Arp2/3 complex. Does not promote actin polymerisation in the absence of membranes (PubMed:29887380). [UniProt]
仅用于科研。不用于诊断过程。未经明确授权不得转售。
篇参考文献 (0)
生物信息学
蛋白别名: Carom; F-BAR and double SH3 domains protein 2; FCH and double SH3 domains protein 2; nervous wreck homolog; NWK1; Protein nervous wreck 1; SH3 multiple domains 3; SH3 multiple domains protein 3; unnamed protein product
基因别名: FCHSD2; KIAA0769; NWK; NWK1; SH3MD3
UniProt ID: (Human) O94868
Entrez Gene ID: (Human) 9873